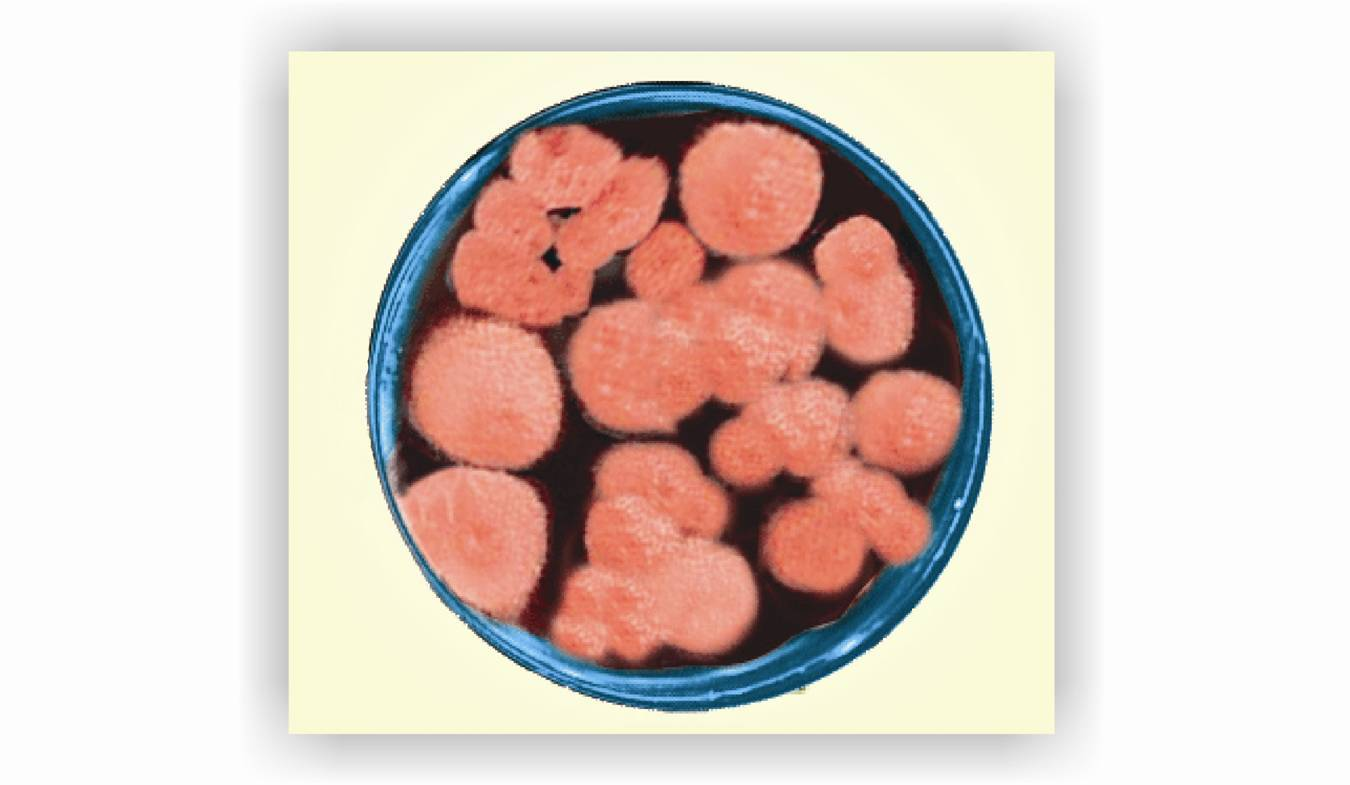
多种现代科学理论,针对红曲菌的单一降血脂作用并且效果缓慢的特点

红曲菌种

典型的红曲霉菌
图片尺寸1280x960
红曲酵母培养物~~促进肉牛肉羊快速生长
图片尺寸1921x1174
红曲霉
图片尺寸438x383
古田养生专用天然高汀红曲米食品菌种天然发酵熬粥泡茶一斤装datk 一
图片尺寸800x800
红曲霉菌的分类
图片尺寸490x366
fm-23红曲米菌种 天然发酵 赤曲 红酒曲福建 产地直销500克
图片尺寸400x400
红曲霉素
图片尺寸583x213
古田高汀食用红曲米食品级菌种天然发酵泡红曲茶熬粥焖饭
图片尺寸1200x1200
"中年危机"之高血脂,纳豆红曲可以帮你渡过
图片尺寸500x376
红曲霉
图片尺寸3648x2736
红曲红色素
图片尺寸1368x1042
红曲霉菌
图片尺寸1080x810
为曲霉科真菌红曲霉 i>monascus purpureus /i> went.
图片尺寸800x527
舌尖上の中药诺贝尔奖认证降血脂圣品红曲
图片尺寸479x480
红曲中提取的"血脂康"降胆固醇,吃点儿天然红曲行不行?_腾讯新闻
图片尺寸869x497
红曲菌是国菌,红曲是国曲也,是中华民族的骄 红曲
图片尺寸600x400
多种现代科学理论,针对红曲菌的单一降血脂作用并且效果缓慢的特点
图片尺寸1350x785
红曲
图片尺寸579x411
一种紫红曲菌种及由其制备红曲粉的方法和制品-爱企查
图片尺寸1673x1665
名医推荐高他汀红曲特殊菌种发酵西药添加老顾顾客食用色素
图片尺寸800x800